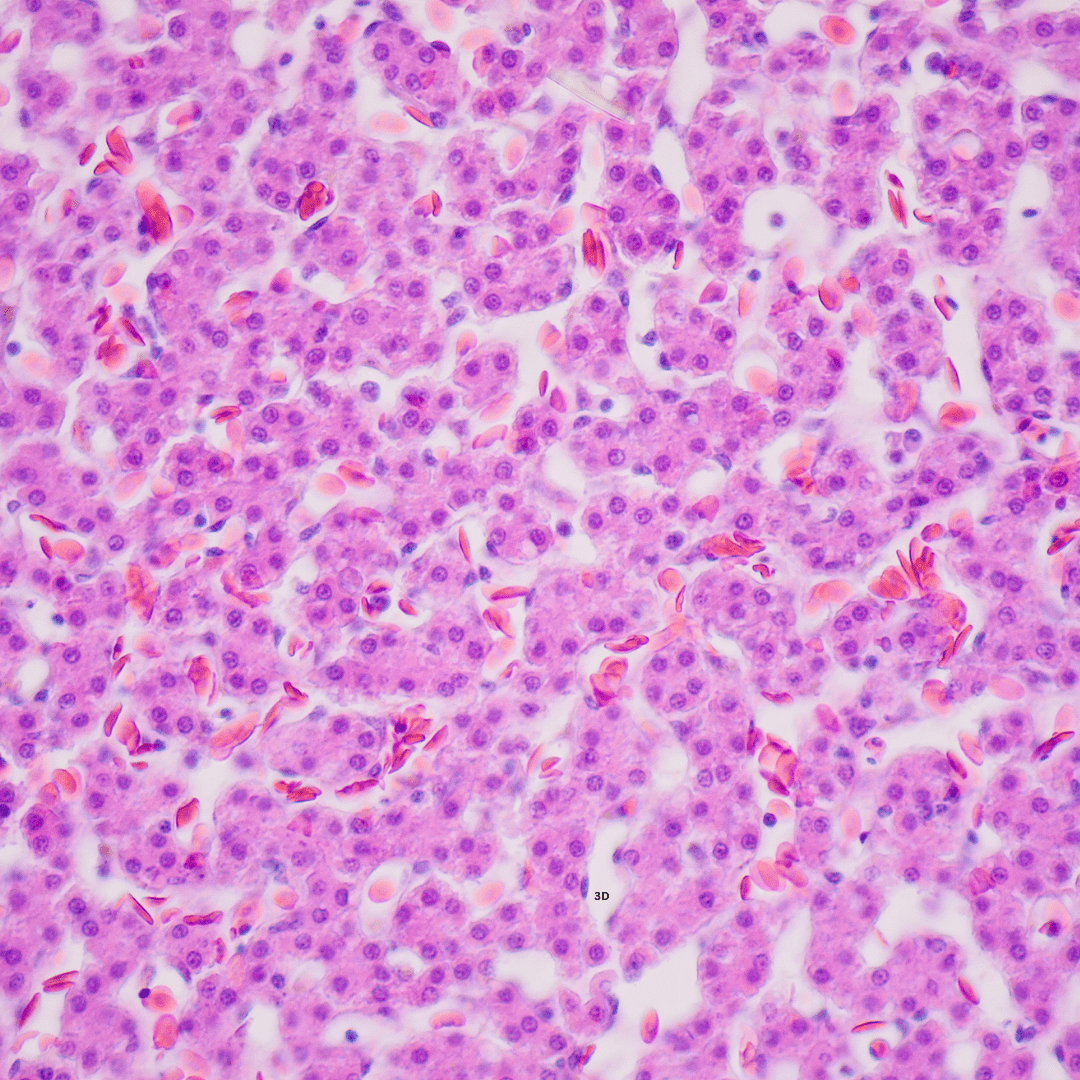

Microspheres & Particles
← Back to all Microspheres and Particles
Polychromatic (PC Red) Red Microspheres
Polysciences’ Fluoresbrite Polychromatic Red Microspheres are internally dyed, monodisperse polystyrene beads exhibiting a broad, excitable red fluorescence; they come as aqueous suspensions (nominal 2.5% solids) in multiple diameters (e.g. 0.5, 1.0, 2.0, 6.0 µm). These microspheres are stable, with narrow fluorescence CVs, leaving the surface available for adsorbing ligands, making them useful for assays, tracer particles, phagocytosis work, and multi-color optical setups.

Collections
-

Bioprocessing, Lipids & Transfection
Find transfection reagents and lipids with various preparations and regulatory tiers to...
-

Electronic Chemicals
Access our portfolio of electronic chemicals, including underfills, encapsulants, and conformal coatings,...
-

Histology, Cytology & Pathology
Explore a comprehensive range of products for histology, cytology, and pathology, including...
-

Instrument Standards
Find instrument standards for analytical instruments like cell analyzers and flow cytometers,...
-

Histology & Microscopy
Equip your lab with our histology and microscopy products, offering high-quality staining...
-

Life Sciences
Discover specialty chemicals and reagents supporting research in histology, microscopy, and anatomic...
-

Microscopy & Electron Microscopy
Delve into our microscopy collections, featuring electron microscopy reagents and accessories essential...
-

Microspheres & Particles
Popular Searches: Polystyrene Microspheres | Silica Microspheres | Carboxyl Microspheres Browse our selection of microspheres...
-

Specialty Chemicals & Adjuncts
Access our range of specialty chemicals and adjuncts, including resins, catalysts, solvents,...